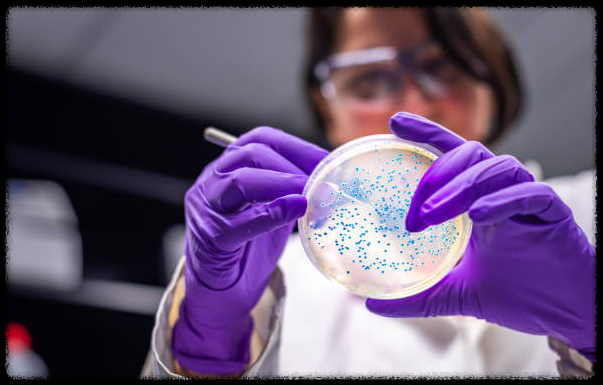

티스토리 뷰
목차

무더위에 더 위험한 식중독, 살모넬라 감염을 피하려면 어떻게 해야 할까요?
7월부터 9월, 지금 이 시기. 한낮의 기온이 치솟는 이때, 혹시 나도 모르게 매일 먹는 음식에서 치명적인 세균에 노출되고 있다는 사실 알고 계셨나요? 최근 식품의약품안전처가 발표한 자료에 따르면 지난 5년간 발생한 살모넬라 식중독 가운데 절반 이상이 여름철에 집중됐다고 밝혔습니다. 특히 달걀과 복합 조리식품에서 주로 발생한 것으로 나타나 일상 속 조리 습관을 다시 점검할 필요가 있습니다. 단순히 겉보기엔 멀쩡한 음식도, 보관과 조리 방식이 조금만 잘못되면 살모넬라균의 온상이 될 수 있습니다. 지금부터 살모넬라 식중독의 원인과 예방수칙, 실생활에서 반드시 실천해야 할 행동을 정리해드립니다.
살모넬라 식중독, 왜 여름철에 집중 발생할까?

2020년부터 2024년까지 살모넬라 식중독은 총 204건 발생했고, 이로 인해 7788명의 환자가 발생했습니다. 그 중에서도 **7월부터 9월까지 발생한 건수는 무려 107건, 전체의 52%**에 해당합니다. 여름철 급격히 상승하는 기온이 살모넬라균의 번식을 촉진하기 때문입니다.
살모넬라균은 가금류, 포유류의 장내, 토양, 물 등 자연환경에 존재할 수 있으며, 특히 날것 상태의 육류나 달걀, 제대로 익히지 않은 조리식품에 존재할 가능성이 높습니다. 고온다습한 날씨가 계속되는 요즘, 조금만 부주의해도 균이 급속도로 번식해 식중독으로 이어질 수 있습니다
.
식중독 발생 장소는 어디? 일상 속에서 발생하는 경로


살모넬라 식중독이 가장 많이 발생한 장소는 음식점으로 129건, 전체의 63%였습니다. 이어서 집단급식소 35건(17%), 즉석판매제조·가공업소 10건(5%) 순으로 나타났습니다.
우리가 자주 찾는 음식점, 도시락 전문점, 뷔페, 고깃집 등에서 실제로 살모넬라균에 노출될 가능성이 가장 높다는 의미입니다. 이는 위생 관리가 조금만 허술해져도 대규모 식중독 사태로 이어질 수 있음을 보여줍니다.
지금 가장 먼저 해야 할 행동은, 외식 후 복통이나 설사 등의 증상이 있을 경우 병원 진료와 함께 식품의약품안전처 또는 관할 보건소에 신고하는 것입니다. 조기 대응이 확산을 막는 유일한 방법입니다.
주의해야 할 식품, 달걀 조리식품이 가장 위험하다


살모넬라 식중독의 주요 원인 식품으로는 달걀 조리식품이 가장 많이 지목됐습니다. 달걀말이, 달걀지단과 같은 음식뿐만 아니라 김밥, 도시락 등 다양한 재료가 함께 조리되는 복합조리식품에서도 빈번하게 발생했습니다.
달걀은 겉보기에 멀쩡해 보여도, 껍질에 살모넬라균이 묻어 있을 수 있고, 조리 과정에서 내부까지 완전히 익히지 않으면 감염 위험이 높아집니다. 특히 김밥용 지단처럼 반숙 상태로 조리되는 경우 더욱 주의가 필요합니다.
이럴 때 중요한 행동 포인트는 달걀은 반드시 노른자와 흰자가 완전히 익을 때까지 가열하고, 식재료 준비 단계에서 손과 조리도구를 세척·소독하는 것입니다.
달걀 안전하게 보관하려면 어떻게 해야 할까?
식약처는 달걀 섭취 자체보다, 달걀의 보관·취급 방법에 따라 살모넬라 감염 위험이 크게 달라진다고 강조합니다.
달걀을 구입할 때는 껍데기가 깨지지 않고, 산란일자와 소비기한이 정확히 표시된 신선한 달걀을 선택해야 합니다.
구입한 후에는 즉시 냉장고에 보관하고, 다른 식재료와의 접촉을 피하기 위해 밀폐 용기에 따로 보관하는 것이 바람직합니다.
음식점이나 급식소처럼 대량 구매가 이뤄지는 곳에서는 특히 상온 방치 금지, 필요량만 구입, 2~4주 이내 소비 등 기본 수칙을 철저히 따라야 합니다.
손 씻기, 단순하지만 가장 강력한 예방 수칙


살모넬라균은 식재료뿐 아니라 사람의 손을 통해 교차오염이 일어나는 경우도 많습니다. 달걀이나 생고기를 만진 손으로 채소를 다루거나 조리된 음식을 만지는 순간, 균은 그대로 음식에 옮겨질 수 있습니다.
음식을 만들기 전과 중간, 달걀·육류·가금류를 만진 뒤에는 반드시 비누를 이용해 흐르는 물에 30초 이상 손을 씻는 것이 필수입니다.
특히 김밥, 샐러드, 도시락처럼 여러 재료가 손을 거쳐 만들어지는 음식은 위생장갑을 수시로 교체해야 하며, 장갑을 착용했다고 해도 손 위생을 소홀히 해서는 안 됩니다.
가열 조리만 제대로 해도 살모넬라균은 사라진다


살모넬라균은 열에 매우 약한 세균입니다. 섭씨 75도 이상에서 1분 이상 가열하면 대부분 사멸됩니다.
하지만 문제는 ‘충분한 조리’ 없이 섭취되는 음식들이 많다는 데 있습니다. 특히 달걀프라이의 반숙, 생고기와 채소를 함께 먹는 메뉴, 익지 않은 김밥 속 재료 등이 대표적입니다.
가정에서 가장 먼저 실천할 수 있는 행동은, 달걀·육류·가금류는 반드시 완전히 익혀 먹는 습관을 들이는 것입니다.
전자레인지 재가열도 중심부까지 충분히 데워야 하며, 냉장·냉동 보관했던 음식은 반드시 재가열 후 섭취하는 것이 안전합니다.
조리기구는 반드시 구분하고 소독까지 해야 합니다


칼, 도마, 수저 등의 조리기구도 살모넬라균의 온상이 될 수 있습니다. 특히 생고기·채소·어류를 동일한 도마나 칼로 조리할 경우, 교차오염 위험이 급격히 상승합니다.
채소용, 육류용, 생선용 조리기구는 구분해서 사용하는 것이 원칙이며, 사용 후에는 열탕 소독이나 식기용 살균제를 이용해 세척해야 합니다.
달걀물이나 반죽을 섞은 용기도 사용 후 즉시 세척·소독하고, 자주 사용하는 주방타월이나 수세미도 주기적인 교체가 필요합니다. 지금 바로 우리 집 주방을 점검해 보세요.
조리자 위생, 식중독 확산을 막는 결정적 변수


음식점과 급식소에서 가장 간과하기 쉬운 부분이 조리자 개인의 건강상태입니다.
구토, 복통, 설사 등의 증상이 있는 조리 종사자는 조리에 참여하지 않도록 관리해야 하며, 증상이 호전된 이후에도 최소 2~3일은 조리 현장에서 배제해야 합니다.
식중독은 조리자 한 명으로부터 수십 명에게 전파될 수 있기 때문에, 음식점 운영자라면 조리 인력의 건강 상태를 반드시 수시로 확인하고, 의심 증상 발생 시 즉시 교체하거나 휴식을 부여해야 합니다.
소비자 입장에서도 위생 상태가 불량한 곳은 피하고, 음식 섭취 전후에 위생 상태를 꼼꼼히 확인하는 습관이 필요합니다.
안전한 여름, 내가 먼저 지켜야 할 생활 속 실천
여름철 식중독, 특히 살모넬라균 감염은 누구에게나 닥칠 수 있습니다. 그러나 생활 속 기본 위생수칙만 잘 지켜도 충분히 예방 가능합니다.
냉장보관, 충분한 가열조리, 철저한 손 씻기, 조리도구 소독 등은 복잡하지도 어렵지도 않습니다.
가장 먼저 실천할 행동은, 달걀 보관상태 확인, 달걀 조리법 점검, 주방 조리기구 정비, 손 씻기 습관 만들기입니다.
이번 여름, 나와 내 가족의 건강을 위해 이 작은 실천들을 꼭 지켜주세요. 지금 하지 않으면, 나중에 반드시 후회하게 될지도 모릅니다.